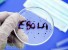

Старый препарат помог ученым открыть новый механизм работы почек
Исследователи из Mayo Clinic обнаружили ранее неизвестный механизм, с помощью которого почки регулируют водный баланс в организме. Это открытие может ...

Созданная искусственным интеллектом универсальная вакцина против коронавирусов успешно прошла первое испытание на людях
Ученые сделали важный шаг на пути к созданию вакцин нового поколения. Исследователи из Кембриджского университета совместно с биотехнологической компа...

Ученые создали биологический «обходной путь» в мозге, который может повысить устойчивость к стрессу
Нарушенные или поврежденные связи между нейронами лежат в основе многих неврологических и психических расстройств. Обычно такие состояния пытаются кор...

Устойчивая к лечению депрессия может поддаваться комбинациям уже известных препаратов
Многие люди с большим депрессивным расстройством не получают заметного облегчения от стандартных методов лечения. Даже современные антидепрессанты пом...

Ученые смогли обратить диабет у мышей с помощью выращенных в лаборатории инсулиновых клеток
Ученые из Швеции сообщили о важном шаге в разработке потенциального метода лечения диабета 1-го типа. Исследователи создали более надежный способ полу...
 Заболевание, спровоцированное вирусом Эбола, зафиксировано экспертами всемирной организации здравоохранения. Несколько случаев зарегистрировано на территории Африки: молодая женщина и 22-летняя студентка института прикладной медицины, скончались от заболевания две недели назад, - сообщили местные СМИ.
Заболевание, спровоцированное вирусом Эбола, зафиксировано экспертами всемирной организации здравоохранения. Несколько случаев зарегистрировано на территории Африки: молодая женщина и 22-летняя студентка института прикладной медицины, скончались от заболевания две недели назад, - сообщили местные СМИ.

Апноэ у ребенка — это нарушение, возникающее во время сна, когда у крохи обнаруживается внезапная остановка дыхания. Это может произойти не
Апноэ у ребенка — это нарушение, возникающее во время сна, когда у крохи обнаруживается внезапная остановка дыхания. Это может произойти не  Вот, вроде бы, и вредителями ос не назовешь, однако досадить могут ничуть не хуже. До поры они бывают незаметными, но в августе их ...
Вот, вроде бы, и вредителями ос не назовешь, однако досадить могут ничуть не хуже. До поры они бывают незаметными, но в августе их ... Учеными давно установлено, что качество сексуальной жизни оказывает влияние на состояние физического и психического здоровья человека. Было
Учеными давно установлено, что качество сексуальной жизни оказывает влияние на состояние физического и психического здоровья человека. Было